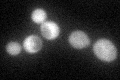
YOL076W
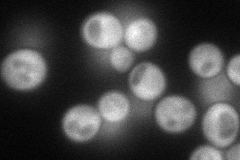
YOL076W
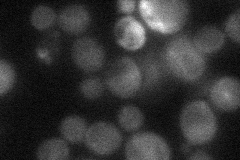
YOL076W
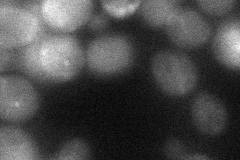
YOL076W
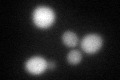
YOL076W
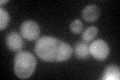
YOL076W
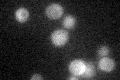
YOL076W

View description
Non-catalytic subunit of the NatB N-terminal acetyltransferase, which catalyzes N-acetylation of proteins with specific N-terminal sequences; involved in mitochondrial inheritance and actin assembly
Localization:
Intensity:
Fold change:
Significance:
-
C’ GFP library in SD
cytosol53.12 -
N' NOP1pr-GFP in SD
cytosol85.5576 -
N' TEF2pr-mCherry in SD

cytosol0 -
N' NATIVEpr-GFP in SD
cytosol31.0743 -
N' TEF2pr-VC and Cyto-VN in SD
cytosol36.3609 -
C’ GFP library in SD+DTT
cytosol51.40.96No -
C’ GFP library in SD+H2O2
cytosol54.891.03No -
C’ GFP library in Starvation Media
cytosol30.880.58No -
C’ GFP library on the background of Pup2-DaMP

cytosol -
C’ GFP library on the background of CCT mutant

cytosol47.49640.894024No
